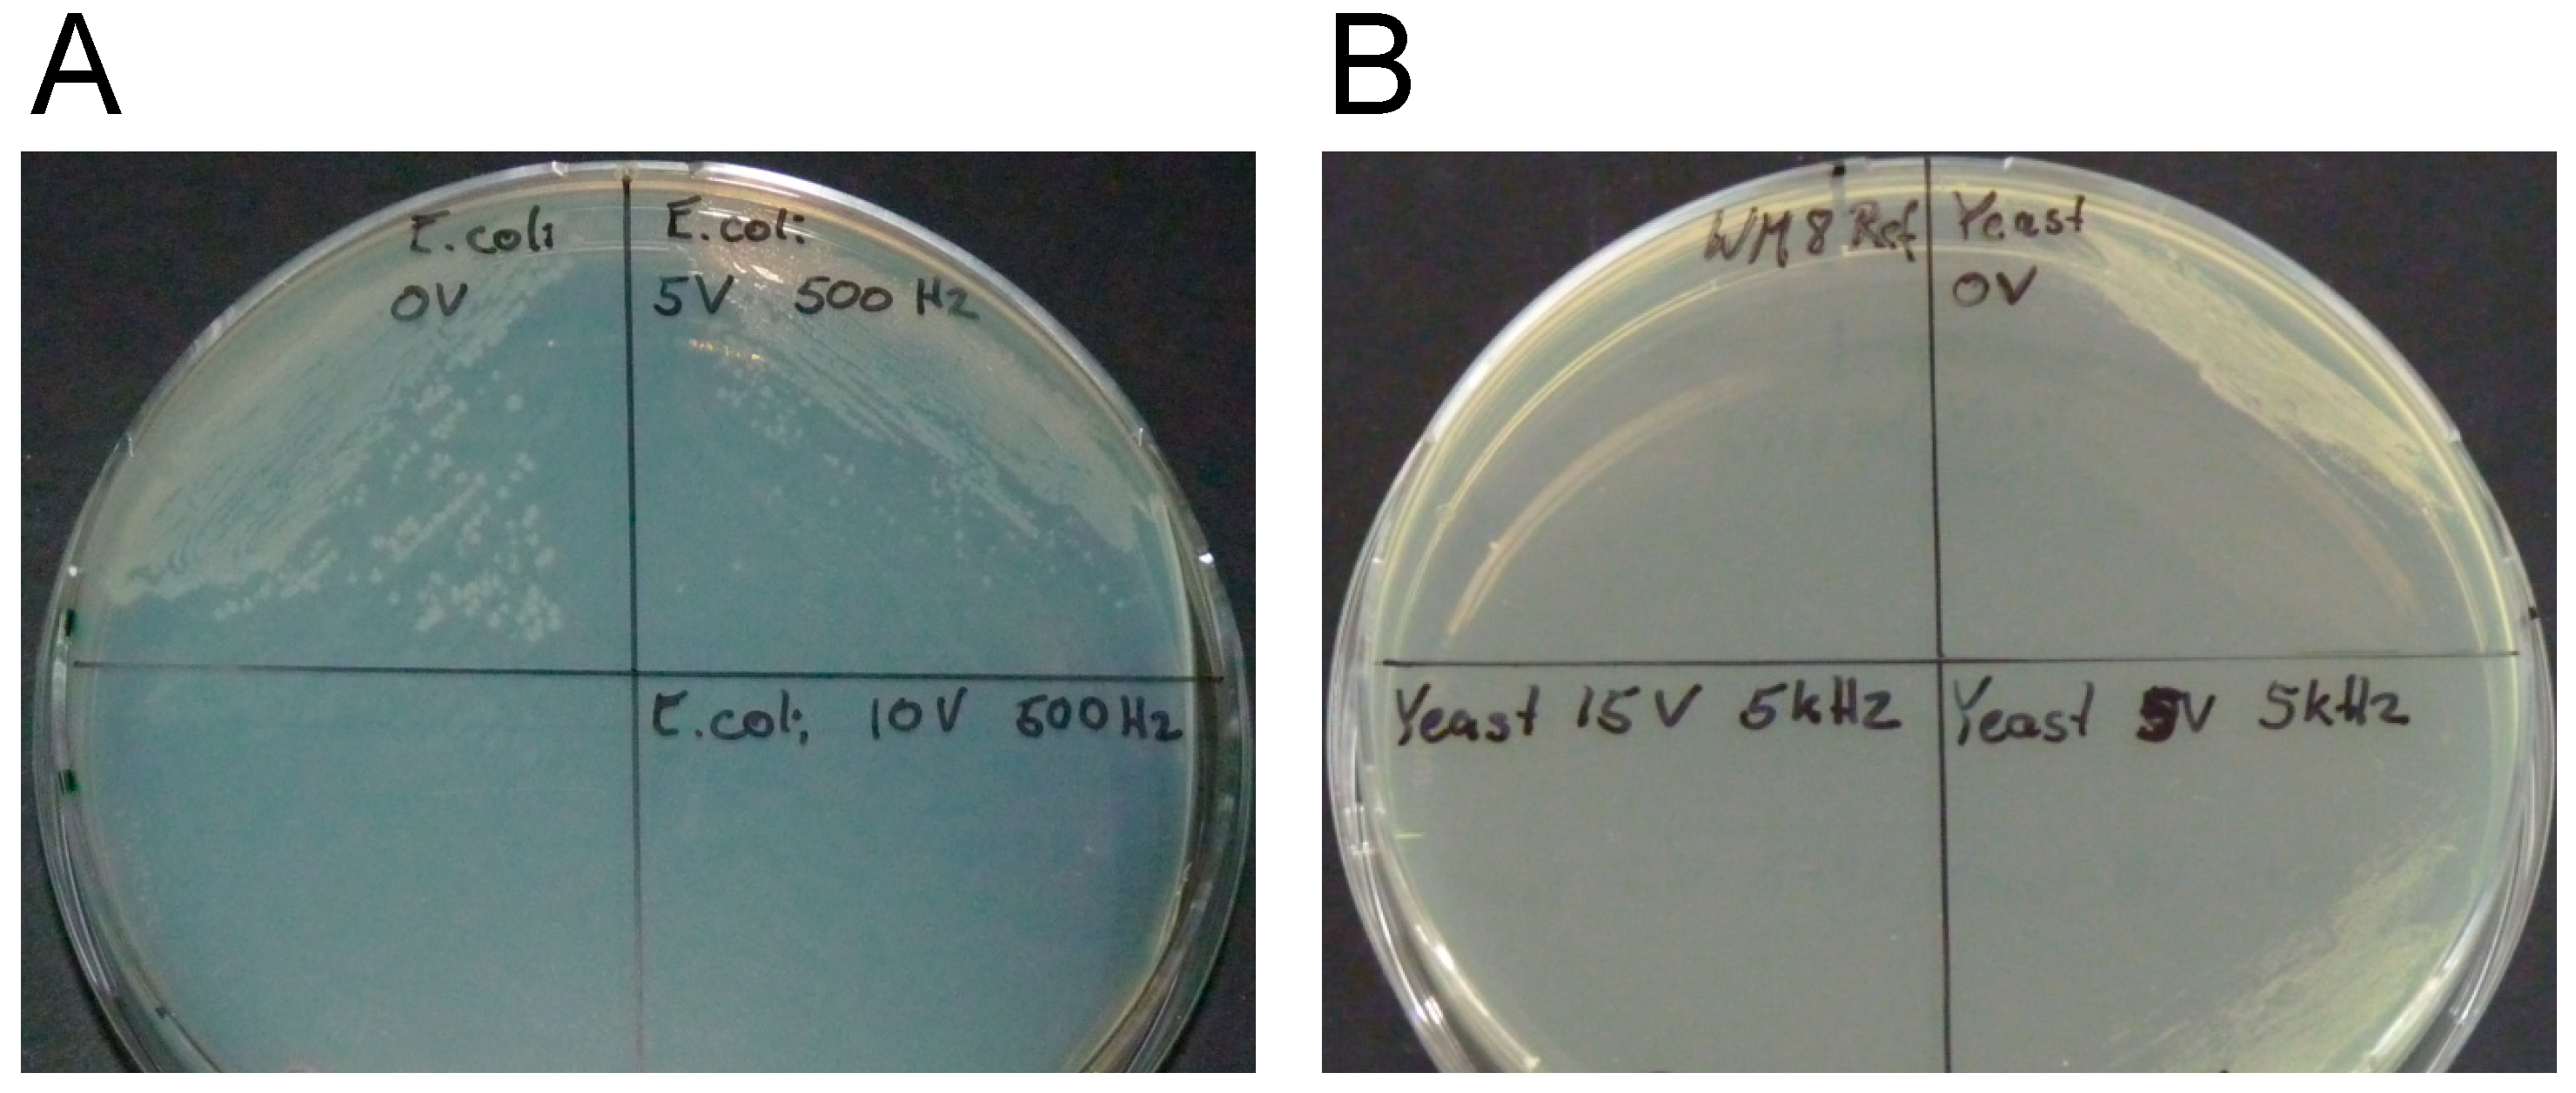
Metabolites 09 00211 g002 Metabolites 09 00211 g002

Microfluidic Irreversible Electroporation—A Versatile Tool to Extract Intracellular Contents of Bacteria and Yeast
Abstract
1. Introduction
2. Results
2.1. Chip Fabrication
2.2. Irreversible Electroporation
2.3. Enhanced Release of Intracellular Contents with Increasing Field Strength
3. Discussion
4. Materials and Methods
4.1. Design of a Microfluidic Device for Irreversible Cell Electroporation
4.2. Application of Electric Pulses
4.3. Microbial Organisms, Media, and Cultivation Conditions
4.4. Sample Processing
4.5. Viability Tests
4.6. Fluorescence Microscopy Test
4.7. Glucose-6-Phosphate (G6P) and Glucose-6-Phosphate Dehydrogenase (G6PDH) Assay
5. Conclusions
Supplementary Materials
Author Contributions
Funding
Conflicts of Interest
References
- Buchholz, A.; Hurlebaus, J.; Wandrey, C.; Takors, R. Metabolomics: Quantification of intracellular metabolite dynamics. Biomol. Eng. 2002, 19, 5–15. [Google Scholar] [CrossRef]
- Reaves, M.L.; Rabinowitz, J.D. Metabolomics in systems microbiology. Curr. Opin. Biotechnol. 2011, 22, 17–25. [Google Scholar] [CrossRef]
- Liu, X.; Locasale, J.W. Metabolomics: A primer. Trends Biochem. Sci. 2017, 42, 274–284. [Google Scholar] [CrossRef]
- Jang, C.; Chen, L.; Rabinowitz, J.D. Metabolomics and isotope tracing. Cell 2018, 173, 822–837. [Google Scholar] [CrossRef]
- Reuss, M.; Aguilera-Vázquez, L.; Mauch, K. Reconstruction of dynamic network models from metabolite measurements. In Metabolomics; Nielsen, J., Jewett, M.C., Eds.; Topics in Current Genetics; Springer: Berlin/Heidelberg, Germany, 2007; pp. 97–124. [Google Scholar]
- De Mey, M.; Taymaz-Nikerel, H.; Baart, G.; Waegeman, H.; Maertens, J.; Heijnen, J.J.; van Gulik, W.M. Catching prompt metabolite dynamics in Escherichia coli with the BioScope at oxygen rich conditions. Metab. Eng. 2010, 12, 477–487. [Google Scholar] [CrossRef]
- Sudarsan, S.; Blank, L.M.; Dietrich, A.; Vielhauer, O.; Takors, R.; Schmid, A.; Reuss, M. Dynamics of benzoate metabolism in Pseudomonas putida KT2440. Metab. Eng. Commun. 2016, 3, 97–110. [Google Scholar] [CrossRef]
- Pinu, F.R.; Villas-Boas, S.G.; Aggio, R. Analysis of intracellular metabolites from microorganisms: Quenching and extraction protocols. Metabolites 2017, 7, 53. [Google Scholar] [CrossRef]
- Schaub, J.; Schiesling, C.; Reuss, M.; Dauner, M. Integrated sampling procedure for metabolome analysis. Biotechnol. Prog. 2006, 22, 1434–1442. [Google Scholar] [CrossRef]
- Theobald, U.; Mailinger, W.; Baltes, M.; Rizzi, M.; Reuss, M. In vivo analysis of metabolic dynamics in Saccharomyces cerevisiae: I. Experimental observations. Biotechnol. Bioeng. 1997, 55, 305–316. [Google Scholar] [CrossRef]
- Noack, S.; Wiechert, W. Quantitative metabolomics: A phantom? Trends Biotechnol. 2014, 32, 238–244. [Google Scholar] [CrossRef]
- Kotnik, T.; Frey, W.; Sack, M.; Haberl Meglic, S.; Peterka, M.; Miklavčič, D. Electroporation-based applications in biotechnology. Trends Biotechnol. 2015, 33, 480–488. [Google Scholar] [CrossRef]
- Lee, W.G.; Demirci, U.; Khademhosseini, A. Microscale electroporation: Challenges and perspectives for clinical applications. Integr. Biol. (Camb.) 2009, 1, 242–251. [Google Scholar] [CrossRef]
- Movahed, S.; Li, D. Microfluidics cell electroporation. Microfluid. Nanofluid. 2011, 10, 703–734. [Google Scholar] [CrossRef]
- Wang, S.; Lee, L.J. Micro-/nanofluidics based cell electroporation. Biomicrofluidics 2013, 7, 011301. [Google Scholar] [CrossRef]
- Bernhardt, J.; Pauly, H. On the generation of potential differences across the membranes of ellipsoidal cells in an alternating electrical field. Biophysik 1973, 10, 89–98. [Google Scholar] [CrossRef]
- Hülsheger, H.; Potel, J.; Niemann, E.G. Electric field effects on bacteria and yeast cells. Radiat. Environ. Biophys. 1983, 22, 149–162. [Google Scholar] [CrossRef]
- Lee, S.W.; Tai, Y.C. Micro cell lysis device. Sens. Actuators A 1999, 73, 74–79. [Google Scholar] [CrossRef]
- Goldberg, A.; Fischer, J.; Rubinsky, B. The Use of Irreversible Electroporation in Food Preservation. In Irreversible Electroporation; Rubinsky, B., Ed.; Series in Biomedical Engineering; Springer: Berlin/Heidelberg, Germany, 2010; pp. 273–312. [Google Scholar]
- Grahl, T.; Märkl, H. Killing of microorganisms by pulsed electric fields. Appl. Microbiol. Biotechnol. 1996, 45, 148–157. [Google Scholar] [CrossRef]
- Lubicki, P.; Jayaram, S. High voltage pulse application for destruction of the gram-negative bacterium Yersinia enterocolitica. Bielectrochem. Bioenerg. 1997, 43, 135–141. [Google Scholar] [CrossRef]
- Moran, U.; Phillips, R.; Milo, R. SnapShot: Key numbers in biology. Cell 2010, 141, 1262–1262.e1. [Google Scholar] [CrossRef]
- Dutreux, N.; Notermans, S.; Wijtzes, T.; Gongora-Nieto, M.M.; Barbosa-Canovas, G.V.; Swanson, B.G. Pulsed electric fields inactivation of attached and free-living. Escherichia coli and Listeria innocua under several conditions. Int. J. Food Microbiol. 2000, 54, 91–98. [Google Scholar] [CrossRef]
- Hülsheger, H.; Niemann, E.G. Lethal effects of High-voltage pulses on E.coli K12. Radiat. Environ. Biophys. 1980, 18, 281–288. [Google Scholar] [CrossRef]
- Hülsheger, H.; Potel, J.; Niemann, E.G. Killing of bacteria with electric pulses of high filed strength. Radiat. Environ. Biophys. 1981, 20, 53–65. [Google Scholar] [CrossRef]
- Sale, A.J.H.; Hamilton, W.A. Effects of high electric fields on microorganisms. I. Killing of bacteria and yeasts. Biochim. Biophys. Acta 1967, 148, 781–788. [Google Scholar] [CrossRef]
- Uchida, S.; Houjo, M.; Tochikubo, F. Efficient sterilization of bacteria by pulse electric field in micro-gap. J. Electrostat. 2008, 66, 427–431. [Google Scholar] [CrossRef]
- Žgalin, M.K.; Hodžić, D.; Reberšek, M.; Kandušer, M. Combination of microsecond and nanosecond pulsed electric field treatments for inactivation of Escherichia coli in water samples. J. Membr. Biol. 2012, 245, 643–650. [Google Scholar] [CrossRef]
- Gášková, D.; Sigler, K.; Janderova, B.; Plasek, J. Effect of high-voltage electric pulses on yeast cells: Factors influencing the killing efficiency. Bioelectrochem. Bioenerg. 1996, 39, 195–202. [Google Scholar] [CrossRef]
- Jacob, H.E.; Förster, W.; Berg, H. Microbiological implications of electric field effects II. Inactivation of yeast cells and repair of their cell envelope. J. Basic Microbiol. 1981, 32, 225–233. [Google Scholar]
- Molinari, P.; Pilosof, A.M.R.; Jagus, R.J. Effect of growth phase and inoculum size on the inactivation of Saccharomyces cerevisiae in fruit juice, by pulsed electric fields. Food Res. Int. 2004, 37, 793–798. [Google Scholar] [CrossRef]
- Rowan, N.J.; MacGregor, S.J.; Anderson, J.G.; Fouracre, R.A.; Farish, O. Pulsed electric field inactivation of diarrhoeagenic Bacillus cereus through irreversible electroporation. Lett. Appl. Microbiol. 2001, 31, 110–114. [Google Scholar] [CrossRef]
- Xiao, S.; Guo, S.; Nesin, V.; Heller, R.; Schoenbach, K.H. Subnanosecond electric pulses cause membrane permeabilization and cell death. IEEE Trans. Biomed. Eng. 2011, 58, 1239–1245. [Google Scholar] [CrossRef] [PubMed]
- Olofsson, J.; Nolkrantz, K.; Ryttsen, F.; Lambie, B.A.; Weber, S.G.; Orwar, O. Single-cell electroporation. Curr. Opin. Biotechnol. 2003, 14, 29–34. [Google Scholar] [CrossRef]
- Fox, M.B.; Esveld, D.C.; Valero, A.; Luttge, R.; Mastwijk, H.C.; Bartels, P.V.; van den Berg, A.; Boom, R.M. Electroporation of cells in microfluidic devices: A review. Anal. Bioanal. Chem. 2006, 385, 474–485. [Google Scholar] [CrossRef] [PubMed]
- Wang, M.; Orwar, O.; Olofsson, J.; Weber, S.G. Single-cell electroporation. Anal. Bioanal. Chem. 2010, 397, 3235–3248. [Google Scholar] [CrossRef] [PubMed]
- Geng, T.; Lu, C. Microfluidic electroporation for cellular analysis and delivery. Lab Chip 2013, 13, 3803–3821. [Google Scholar] [CrossRef] [PubMed]
- Santra, T.S.; Tseng, F.G. Recent trends on micro/nanofluidic single cell electroporation. Micromachines 2013, 4, 333–356. [Google Scholar] [CrossRef]
- Hsieh, H.Y.; Camci-Unal, G.; Huang, T.W.; Liao, R.; Chen, T.J.; Paul, A.; Tseng, F.G.; Khademhosseini, A. Gradient static-strain stimulation in a microfluidic chip for 3D cellular alignment. Lab Chip 2014, 14, 482–493. [Google Scholar] [CrossRef] [PubMed]
- Nan, L.; Jiang, Z.; Wei, X. Emerging microfluidic devices for cell lysis: A review. Lab Chip 2014, 14, 1060–1073. [Google Scholar] [CrossRef]
- Chang, L.; Li, L.; Shi, J.; Sheng, Y.; Lu, W.; Gallego-Perez, D.; Lee, L.J. Micro-/nanoscale electroporation. Lab Chip 2016, 16, 4047–4062. [Google Scholar] [CrossRef]
- Sang, K.K.; Jae, H.K.; Kwang, P.K.; Taek, D.C. Continuous low-voltage DC electroporation on a microfluidic chip with polyelectrolytic salt bridges. Anal. Chem. 2007, 79, 7761–7766. [Google Scholar]
- Mernier, G.; Martinez-Duarte, R.; Lehal, R.; Radtke, F.; Renoud, P. Very high throughput electrical cell lysis and extraction of intracellular compounds using 3D carbon electrodes in Lab-On-A-Chip devices. Micromachines 2012, 3, 574–581. [Google Scholar] [CrossRef]
- Lu, H.; Schmidt, M.A.; Jensen, K.F. A microfluidic electroporation device for cell lysis. Lab Chip 2005, 5, 23–29. [Google Scholar] [CrossRef] [PubMed]
- Wang, H.; Lu, C. Electroporation of mammalian cells in a microfluidic channel with geometric variation. Chem. Anal. 2006, 78, 5158–5164. [Google Scholar] [CrossRef] [PubMed]
- Wang, H.Y.; Bhunia, A.K.; Lu, C. A microfluidic flow-through device for high throughput electrical lysis of bacterial cells based on continuous DC voltage. Biosens. Bioelectron. 2006, 22, 582–588. [Google Scholar] [CrossRef] [PubMed]
- Hung, M.S.; Chang, Y.T. Single cell lysis and DNA extending using electroporation microfluidic device. Biochip J. 2012, 6, 84–90. [Google Scholar] [CrossRef]
- Ramadan, Q.; Samper, V.; Poenar, D.; Liang, Z.; Yu, C.; Lim, T.M. Simultaneous cell lysis and bead trapping in a continuous flow microfluidic device. Sens. Actuators B 2006, 113, 944–955. [Google Scholar] [CrossRef]
- Bao, N.; Kodippili, G.C.; Giger, K.M.; Fowler, V.M.; Low, P.S.; Lu, C. Single-cell electrical lysis of erythrocytes detects deficiencies in the cytoskeletal protein network. Lab Chip 2011, 11, 3053–3056. [Google Scholar] [CrossRef] [PubMed]
- Bürgel, S.C.; Escobedo, C.; Haandbæk, N.; Hierlemann, A. On-chip electroporation and impedance spectroscopy of single-cells. Sens. Actuators B 2015, 210, 82–90. [Google Scholar]
- Filla, L.A.; Sanders, K.L.; Filla, R.T.; Edwards, J.L. Automated sample preparation in a microfluidic culture device for cellular metabolomics. Analyst 2016, 141, 3858–3865. [Google Scholar] [CrossRef]
- Rajabi, N.; Bahnemann, J.; Tzeng, T.N.; Barradas, O.P.; Zeng, A.P.; Müller, J. Lab-on-a-chip for cell perturbation, lysis, and efficient separation of sub-cellular components in a continuous flow mode. Sens. Actuators A 2014, 215, 136–143. [Google Scholar] [CrossRef]
- Wang, J.; Zhan, Y.; Ugaz, V.M.; Lu, C. Vortex-assisted DNA delivery. Lab Chip 2010, 10, 2057–2061. [Google Scholar] [CrossRef]
- Wang, S.; Zhang, X.; Wang, W.; Lee, L.J. Semicontinuous flow electroporation chip for high-throughput transfection on mammalian cells. Anal. Chem. 2009, 81, 4414–4421. [Google Scholar] [CrossRef][Green Version]
- Wang, H.Y.; Lu, C. Microfluidic electroporation for delivery of small molecules and genes into cells using a common DC power supply. Biotechnol. Bioeng. 2008, 100, 579–586. [Google Scholar] [CrossRef]
- Hu, N.; Yang, J.; Qian, S.; Jo, S.W.; Zheng, X. A cell electrofusion microfluidic device integrated with 3D thin-film microelectrode arrays. Biomicrofluidics 2011, 5, 1–12. [Google Scholar] [CrossRef]
- Geveke, D.; Kozempel, M.F. Pulsed electric field effects on bacteria and yeast cells. J. Food Proc. Preserv. 2003, 27, 65–72. [Google Scholar] [CrossRef]
- Potter, H.; Weir, L.; Leder, P. Enhancer-dependent expression of human kappa immunoglobulin genes introduced into mouse pre-B lymphocytes by electroporation. Proc. Natl. Acad. Sci. USA 1984, 81, 7161–7165. [Google Scholar] [CrossRef]
- Pliquet, U.; Gift, E.A.; Weaver, C. Determination of the electric field and anomalous heating caused by exponential pulses with aluminum electrodes in electroporation experiments. Bioelectrochem. Bioenerg. 1996, 39, 39–53. [Google Scholar] [CrossRef]
- El Zakhem, H.; Lanoisellé, J.-L.; Lebovka, N.I.; Nonus, M.; Vorobiev, E. The early stages of Saccharomyces cerevisiae yeast suspensions damage in moderate pulsed electric fields. Colloids Surf. B Biointerfaces 2006, 47, 189–197. [Google Scholar] [CrossRef]
- Novickij, V.; Grainys, A.; Lastauskienė, E.; Kananavičiūtė, R.; Pamedytytė, D.; Kalėdienė, L.; Novickij, J.; Miklavčič, D. Pulsed electromagnetic field assisted in vitro electroporation: A pilot study. Sci. Rep. 2016, 6, 33537. [Google Scholar] [CrossRef][Green Version]
- Pothakamury, U.R.; Monsalve-González, A.; Barbosa-Cánovas, G.V.; Swanson, B.G. Inactivation of Escherirchia coli and Staphylococus aureus in model foods by pulsed electric field technology. Food Res. Int. 1995, 28, 167–171. [Google Scholar] [CrossRef]
- Golberg, A.; Belkin, M.; Rubinsky, B. Irreversible electroporation for microbial control of drugs in solution. AAPS Pharm. Sci. Tech. 2009, 10, 881–886. [Google Scholar] [CrossRef] [PubMed][Green Version]
- Schoenbach, K.H.; Peterkin, F.E.; Alden, R.W., III; Beebe, S.J. The effect of pulsed electric fields on biological cells: Experiments and applications. IEEE Trans. Plasma Sci. 1997, 25, 284–292. [Google Scholar] [CrossRef]
- Korem, M.; Goldberg, N.S.; Cahan, A.; Cohen, M.J.; Nissenbaum, I.; Moses, A.E. Clinically applicable irreversible electroporation for eradication of micro-organisms. Lett. Appl. Microbiol. 2018, 67, 15–21. [Google Scholar] [CrossRef] [PubMed]
- Nanchen, A.; Schicker, A.; Sauer, U. Nonlinear dependency of intracellular fluxes on growth rate in miniaturized continuous cultures of Escherichia coli. Appl. Eniviron. Microbiol. 2006, 72, 1164–1172. [Google Scholar] [CrossRef] [PubMed]
- Klein, T.; Schneider, K.; Heinzle, E. A system of miniaturized stirred bioreactors for parallel continuous cultivation of yeast with online measurement of dissolved oxygen and off-gas. Biotechnol. Bioeng. 2013, 110, 535–542. [Google Scholar] [CrossRef] [PubMed]
- Schmideder, A.; Severin, T.S.; Cremer, J.H.; Weuster-Botz, D. A novel milliliter-scale chemostat system for parallel cultivation of microorganisms in stirred-tank bioreactors. J. Biotechnol. 2015, 210, 19–24. [Google Scholar] [CrossRef]
- Kildegaard, K.R.; Jensen, N.B.; Schneider, K.; Czarnotta, E.; Özdemir, E.; Klein, T.; Maury, J.; Ebert, B.E.; Christensen, H.B.; Chen, Y.; et al. Engineering and systems-level analysis of Saccharomyces cerevisiae for production of 3-hydroxypropionic acid via malonyl-CoA reductase-dependent pathway. Microb. Cell Fact. 2016, 15, 53. [Google Scholar] [CrossRef] [PubMed]
- Blank, L.M. Let’s talk about flux or the importance of (intracellular) reaction rates. Microb. Biotechnol. 2017, 10, 28–30. [Google Scholar] [CrossRef]
- Link, H.; Fuhrer, T.; Gerosa, L.; Zamboni, N.; Sauer, U. Real-time metabolome profiling of the metabolic switch between starvation and growth. Nat. Methods 2015, 12, 1091–1097. [Google Scholar] [CrossRef]
- Datsenko, K.A.; Wanner, B.L. One-step inactivation of chromosomal genes in Escherichia coli K-12 using PCR products. Proc. Natl. Acad. Sci. USA 2000, 97, 6640–6645. [Google Scholar] [CrossRef]
- Sambrook, J.; Russell, D.W. Molecular Cloning: A Laboratory Manual; Cold Spring Harbor Laboratory Press: Woodbury, NY, USA, 2001. [Google Scholar]
- Lang, C.; Looman, A.C. Efficient expression and secretion of Aspergillus niger RH5344 polygalacturonase in Saccharomyces cerevisiae. Appl. Microbiol. Biotechnol. 1995, 44, 147–156. [Google Scholar] [CrossRef]

© 2019 by the authors. Licensee MDPI, Basel, Switzerland. This article is an open access article distributed under the terms and conditions of the Creative Commons Attribution (CC BY) license (http://creativecommons.org/licenses/by/4.0/).
Share and Cite
Rockenbach, A.; Sudarsan, S.; Berens, J.; Kosubek, M.; Lazar, J.; Demling, P.; Hanke, R.; Mennicken, P.; Ebert, B.E.; Blank, L.M.; et al. Microfluidic Irreversible Electroporation—A Versatile Tool to Extract Intracellular Contents of Bacteria and Yeast. Metabolites 2019, 9, 211. https://doi.org/10.3390/metabo9100211
Rockenbach A, Sudarsan S, Berens J, Kosubek M, Lazar J, Demling P, Hanke R, Mennicken P, Ebert BE, Blank LM, et al. Microfluidic Irreversible Electroporation—A Versatile Tool to Extract Intracellular Contents of Bacteria and Yeast. Metabolites. 2019; 9(10):211. https://doi.org/10.3390/metabo9100211
Chicago/Turabian StyleRockenbach, Alexander, Suresh Sudarsan, Judith Berens, Michael Kosubek, Jaroslav Lazar, Philipp Demling, René Hanke, Philip Mennicken, Birgitta E. Ebert, Lars M. Blank, and et al. 2019. "Microfluidic Irreversible Electroporation—A Versatile Tool to Extract Intracellular Contents of Bacteria and Yeast" Metabolites 9, no. 10: 211. https://doi.org/10.3390/metabo9100211
APA StyleRockenbach, A., Sudarsan, S., Berens, J., Kosubek, M., Lazar, J., Demling, P., Hanke, R., Mennicken, P., Ebert, B. E., Blank, L. M., & Schnakenberg, U. (2019). Microfluidic Irreversible Electroporation—A Versatile Tool to Extract Intracellular Contents of Bacteria and Yeast. Metabolites, 9(10), 211. https://doi.org/10.3390/metabo9100211





